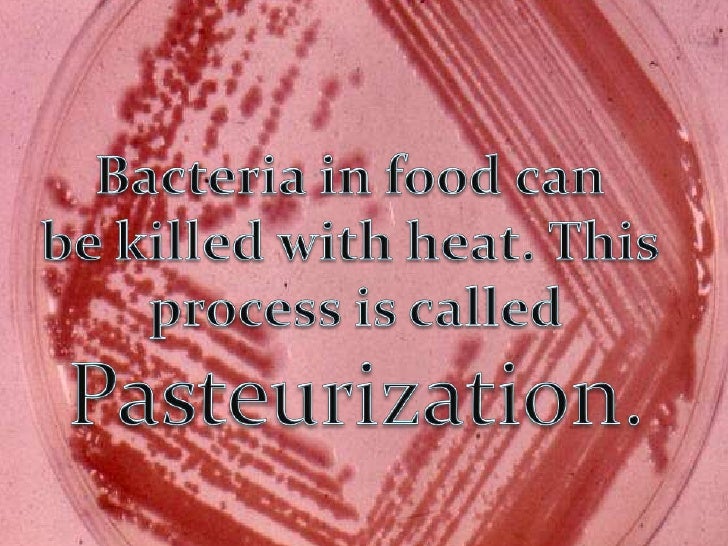
Final Presentation For Ci776 For Slideshare

If you are looking for NEW upscreen Bacteria Shield Matte Displayschutz Schutzfolie Volkswag… you've visit to the right page. We have 9 Images about NEW upscreen Bacteria Shield Matte Displayschutz Schutzfolie Volkswag… like NEW upscreen Bacteria Shield Matte Displayschutz Schutzfolie Volkswag…, BEST BUY upscreen Bacteria Shield Matte Displayschutzfolie passend f and also Gemma Calzada. La nutrition inadĂ©quate et les toxiques comme origine. Read more:
NEW Upscreen Bacteria Shield Matte Displayschutz Schutzfolie Volkswag…

bacteria schutzfolie upscreen displayschutz shield
Gemma Calzada. La Nutrition Inadéquate Et Les Toxiques Comme Origine

Psoriasis 2014

psoriasis
Prebiotics Ingredients Market: Promotes Good Bacteria And Are High In…

prebiotics bacteria
Disease Transmission And Cycle

modes indirect borne
Gemma Calzada. La Nutrition Inadéquate Et Les Toxiques Comme Origine

Final Presentation For Ci776 For Slideshare
BEST BUY Upscreen Bacteria Shield Matte Displayschutzfolie Passend F

Carbohydrates

carbohydrates
Gemma calzada. la nutrition inadĂ©quate et les toxiques comme origine. Modes indirect borne. Prebiotics ingredients market: promotes good bacteria and are high in…